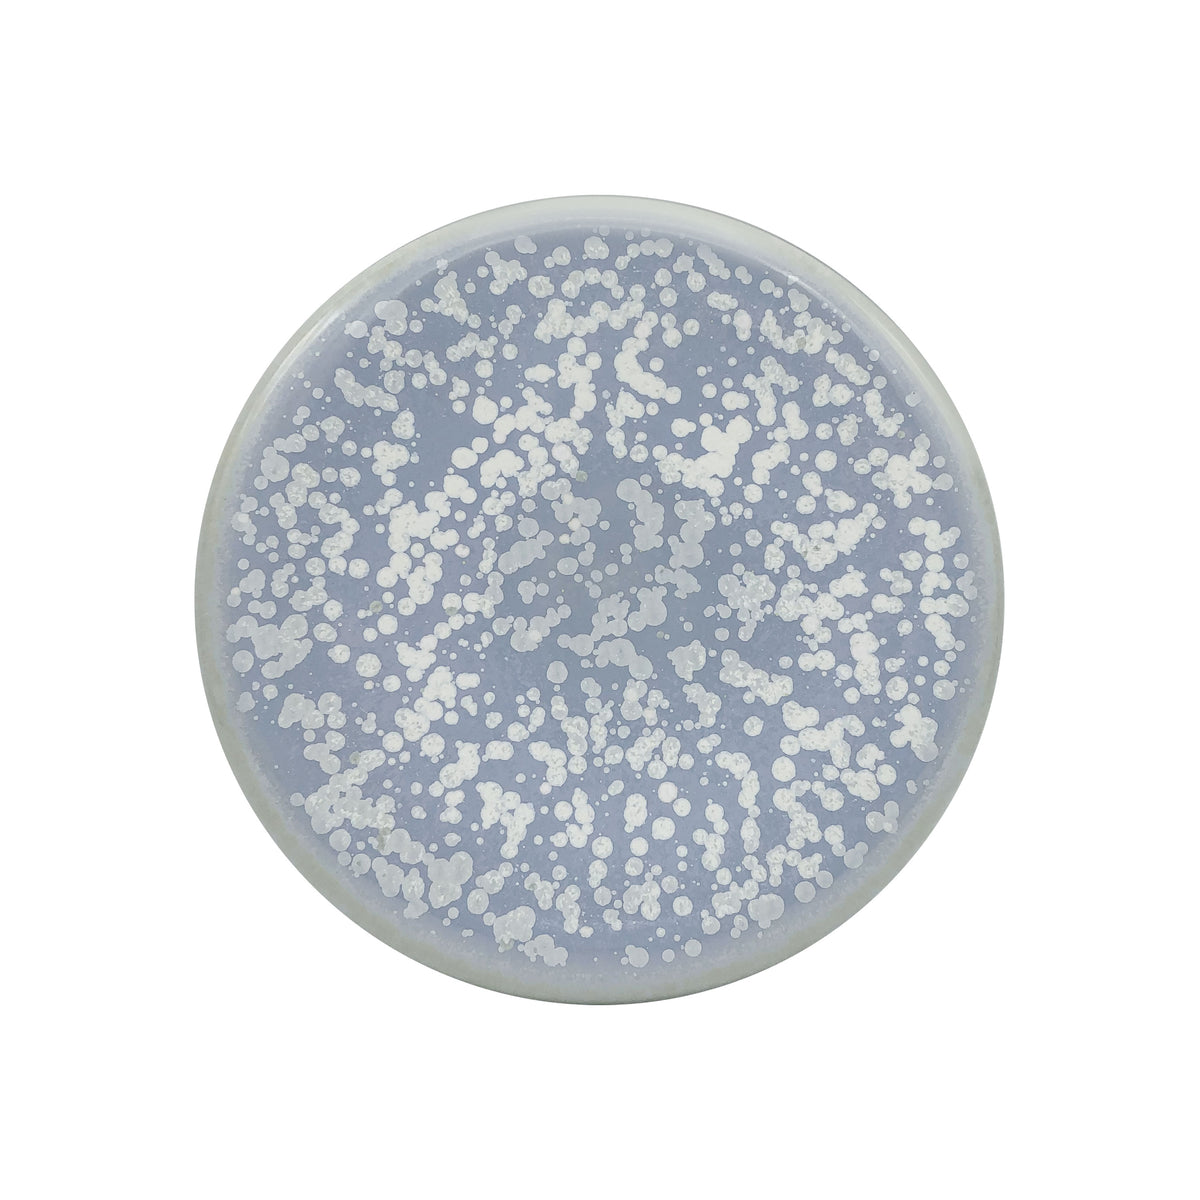

Dirty
SONG Océan - Dinner plate mini Bubble
Ref : BUB1008SGOCSGOC000
BUB1008SGOCSGOC000
ø 16.5 cm
$270.00 USD
More information

Iconic product of our brands, Bubble is now enhancing its range with an elegant and completly flat plate which will provide multi possibilities in terms of presentation, from starters to desserts.
Care
MICRO-WORDS
Our porcelain pieces have been fired at 1400°C and can therefore perfectly resist to high temperatures.
All our models are microwave-safe with the exception of those decorated with precious metals (gold, silver or platinum).
However, beware of temperature differences between hot and cold (e.g. from the refrigerator to the oven), the piece could crack.
DISHWASHER
All our models are dishwasher-safe without damage with the exception of those decorated with precious metals (gold, silver or platinum). Be sure to choose a low-temperature program and respect the recommended product dosage. Make sure that the pieces do not collide.
For hand cleaning, we recommend the use of a soft sponge and a standard dishwashing liquid.
Delivery & Return
Shipping in Metropolitan France
Shipping done in five working days after validation of your order.
Free delivery from 100 euros of purchase for metropolitan France (including Corsica and Monaco).
Shipping in Europe
The sale on our e-shop is possible from the following countries:
Germany, Belgium, Denmark, Spain, Finland, Great Britain,
Greece, Ireland, Italy, Luxembourg, Netherlands, Portugal, Sweden and Switzerland.
Shipping done in seven working days after validation of your order.
Checks to be undertaken on delivery
The Customer must check, before proceeding to the signature of the delivery order :
- The apparent condition of the package(s).
- The condition of the products inside the package(s).
- The good conformity of the products compared to the delivery order on the one hand and the ordered goods on the other hand.
In the absence of any specific reservations made by the Customer, delivery will be deemed as compliant.
For further details, please read article 8 “Delivery” of our General terms and conditions of sale.
Return & withdrawal.
In the event that the product purchased online does not suit you, you can exercise your right of withdrawal, without having to justify your decision, up to fourteen days after receipt of the item concerned.
You will then be responsible for the cost of returning the item. The refund will be made within fourteen days of receipt of the returned items. It is specified that no refund is made in store.
For further details, please read article 9 “Right of withdrawal” of our General terms and conditions of sale.